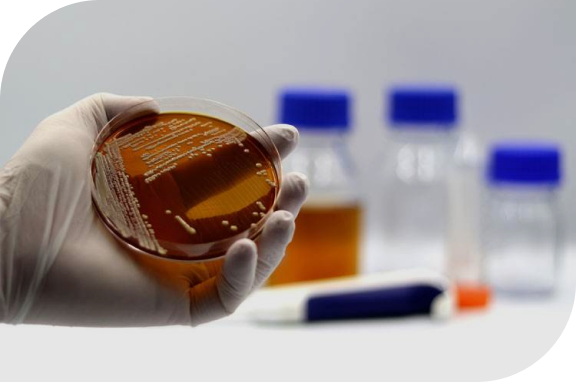

Was tun bei Durchfall?

Durchfall – Definition und Ursachen
Bei Babys ist Stuhlgang zwischen einmal alle fünf Tage und fünfmal täglich nicht ungewöhnlich, bei Erwachsenen wird ab mehr als drei weichen Stuhlgängen am Tag von Diarrhö gesprochen. Dafür können Infektionen mit Viren (wie Rota- oder Noroviren) oder Bakterien (beispielsweise Salmonellen oder Escherichia coli) verantwortlich sein, seltener sind Parasiten die Auslöser des Durchfalls. Auch Reisedurchfall wird meist durch Viren oder Bakterien verursacht. Doch auch Nahrungsmittelunverträglichkeiten, Stress oder auch die Behandlung mit Antibiotika können zu Durchfall führen.

Behandlung von Durchfall
Diarrhö schwächt den Körper, da er Flüssigkeit und Salze verliert. Doch was tun bei Durchfall? Am wichtigsten ist es, diese Verluste auszugleichen. Der Körper benötigt eine ausreichende Zufuhr von Flüssigkeit, beispielsweise in Form von Wasser, Tee oder Gemüsebrühe. Bei starkem Durchfall können orale Rehydratationslösungen aus der Apotheke den Körper mit Flüssigkeit und Elektrolyten versorgen. Auch Schonkost, wie beispielsweise Banane, geriebener Apfel, Haferbrei oder Möhrensuppe, konnten sich bei Durchfall bewähren. Außerdem bieten Arzneimittel wie Perenterol® eine verträgliche Behandlung von Diarrhö. Allerdings ist bei Kindern unter zwei Jahren, Schwangeren und Senioren aufgrund der erhöhten Gefahr der Dehydratation bei Durchfall grundsätzlich ein Arzt aufzusuchen. Auch wenn die Diarrhö länger als zwei Tage anhält, Fieber hinzukommt oder Bewusstseinsstörungen oder Kreislaufbeschwerden auftreten, muss ein Arzt aufgesucht werden. Gleiches gilt, wenn der Stuhl mit Schleim oder Blut versetzt ist.
Perenterol®
Die Wirkung von Perenterol® beruht auf der Arznei-Hefe Saccharomyces boulardii. Dank ihres besonderen Herstellungsverfahrens zeichnet sie sich durch ihre schnelle Reaktivierung im Darm aus, zudem ist sie wärmeunempfindlich und somit für warme Urlaubsziele geeignet. Die Hefe neutralisiert bakterielle Giftstoffe, bindet die Erreger des Durchfalls und unterstützt den Körper dabei, sie auszuscheiden. Auf diese Weise kann die Diarrhö bekämpft werden, ohne die natürliche Bewegung des Darms zu behindern, wie es bei sogenannten Motilitätshemmern geschieht. Das macht Perenterol® zu einem verträglichen Mittel gegen Durchfall, sodass es bereits bei Kindern ab zwei Jahren angewendet werden kann. Zudem kann das Mittel auch zur Vorbeugung von Reisedurchfall sowie Durchfall unter Sondenernährung oder Antibiotika-Einnahme verwendet werden. Nach Absprache mit einem Arzt kann Perenterol® Junior zur Behandlung akuter Durchfälle bereits für Babys ab 6 Monaten eingesetzt werden.
Anwendung von Perenterol®
Ab einem Alter von zwei Jahren kann ein- bis zweimal täglich eine Perenterol® forte 250 mg Kapsel eingenommen werden. Zur Vorbeugung von Reisedurchfall kann die Behandlung bereits fünf Tage vor dem Start der Reise begonnen werden. Dafür werden die Kapseln unzerkaut mit ausreichend Flüssigkeit eingenommen. Auch jüngere Kinder ab sechs Monaten können nach Rücksprache mit einem Arzt mit Perenterol® Junior 250 mg Pulver behandelt werden. Zur Behandlung akuter Durchfälle kann ein- bis zweimal täglich das Pulver eines Beutels in ein Getränk oder eine Speise (auf Zimmertemperatur) eingerührt werden.
Perenterol®
jetzt online erhältlich
Bestellen Sie noch heute Perenterol® online und lassen Sie es sich bequem nach Hause liefern.
Jetzt kaufen